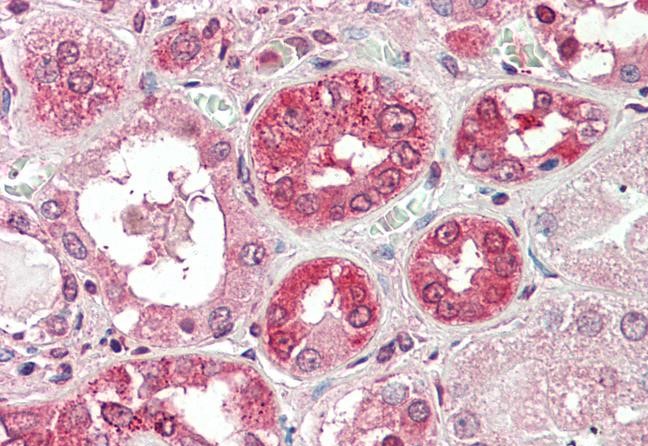
Anti-COG8 Antibody

Goat anti-COG8
EB08923
ApplicationsELISA, ImmunoHistoChemistry
Product group Antibodies
TargetCOG8
Overview
- SupplierEverest Biotech
- Product NameGoat anti-COG8 Antibody
- Delivery Days Customer5
- ApplicationsELISA, ImmunoHistoChemistry
- Applications SupplierPep-ELISA, IHC
- CertificationResearch Use Only
- ClonalityPolyclonal
- Concentration0.5 mg/ml
- Gene ID84342
- Target nameCOG8
- Target descriptioncomponent of oligomeric golgi complex 8
- Target synonymsCDG2H, DOR1, conserved oligomeric Golgi complex subunit 8, COG complex subunit 8, conserved oligomeric golgi complex component 8, dependent on RIC1
- HostGoat
- Scientific DescriptionRefSeq number(s): NP_115758.3. Purification: Antigen affinity purified. Names and symbols: COG8; component of oligomeric golgi complex 8; DOR1; FLJ22315; conserved oligomeric golgi complex component 8; dependent on RIC1
- Reactivity SupplierHuman
- Storage Instruction-20°C
- UNSPSC12352203